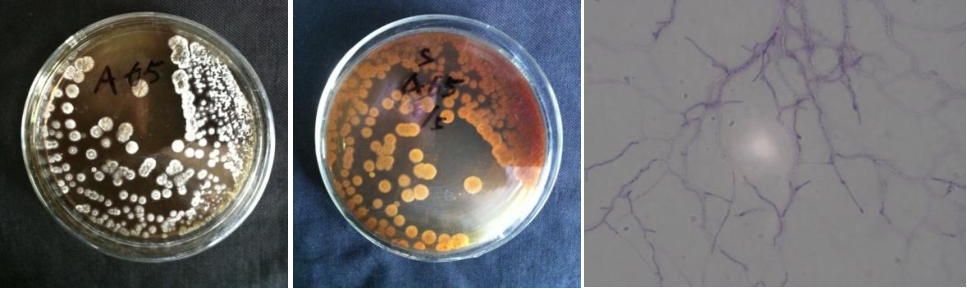

Loading...
| StrainNO | A65 |
| Classification | Streptomyces |
| 16s rDNA sequence | GGTGGTTGCTTAACACATGCAAGTCGAACGATGAACCTCCTTCGGGAGGGGATTAGTGGCGAACGGGTGAGTAACACGTGGGCA ATCTGCCCTGCACTCTGGGACAAGCCCTGGAAACGGGGTCTAATACCGGATACAACCACTGGGGGCATCCTCTGGTGGTGGAAA GCTCCGGCGGTGCAGGATGAGCCCGCGGCCTATCAGCTAGTTGGTGAGGTAACGGCTCACCAAGGCGACGACGGGTAGCCGGCC TGAGAGGGCGACCGGCCACACTGGGACTGAGACACGGCCCAGACTCCTACGGGAGGCAGCAGTGGGGAATATTGCACAATGGGC GAAAGCCTGATGCAGCGACGCCGCGTGAGGGATGACGGCCTTCGGGTTGTAAACCTCTTTCAGCAGGGAAGAAGCGAAAGTGAC GGTACCTGCAGAAGAAGCGCCGGCTAACTACGTGCCAGCAGCCGCGGTAATACGTAGGGCGCAAGCGTTGTCCGGAATTATTGG GCGTAAAGAGCTCGTAGGCGGCTTGTCACGTCGGTTGTGAAAGCCCGGGGCTTAACCCCGGGTCTGCAGTCGATACGGGCAGGC TAGAGTTCGGTAGGGGAGATCGGAATTCCTGGTGTAGCGGTGAAATGCGCAGATATCAGGAGGAACACCGGTGGCGAAGGCGGA TCTCTGGGCCGATACTGACGCTGAGGAGCGAAAGCGTGGGGAGCGAACAGGATTAGATACCCTGGTAGTCCACGCCGTAAACGG TGGGCACTAGGTGTGGGCAACATTCCACGTTGTCCGTGCCGCAGCTAACGCATTAAGTGCCCCGCCTGGGGAGTACGGCCGCAA GGCTAAAACTCAAAGGAATTGACGGGGGCCCGCACAAGCGGCGGAGCATGTGGCTTAATTCGACGCAACGCGAAGAACCTTACC AAGGCTTGACATACACCGGAAACATCCAGAGATGGGTGCCCCCTTGTGGTCGGTGTACAGGTGGTGCATGGCTGTCGTCAGCTC GTGTCGTGAGATGTTGGGTTAAGTCCCGCAACGAGCGCAACCCTTGTCCCGTGTTGCCAGCAGGCCCTTGTGGTGCTGGGGACT CACGGGAGACCGCCGGGGTCAACTCGGAGGAAGGTGGGGACGACGTCAAGTCATCATGCCCCTTATGTCTTGGGCTGCACACGT GCTACAATGGCCGGTACAATGAGCTGCGATACCGCGAGGTGGAGCGAATCTCAAAAAGCCGGTCTCAGTTCGGATTGGGGTCTG CAACTCGACCCCATGAAGTCGGAGTCGCTAGTAATCGCAGATCAGCATTGCTGCGGTGAATACGTTCCCGGGCCTTGTACACAC CGCCCGTCACGTCACGAAAGTCGGTAACACCCGAAGCCGGTGGCCCAACCCCTTGTGGGAGGGAGCTGTCGAAGGTGGGACTGG CGATTGGGACGAGGTCGTAACAA |
| Strain Morphology Photos | |
| Morphological Description | hyphae branch;flourish;apart;many vacuoles;no spore chains;hyphae vacuole;large;clusters;ends of mycelium bunched;spore pile bare;front and back light brown |